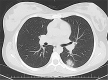

Imaging Findings of SARS-CoV-2 Infection in Pediatrics: A Systematic Review of Coronavirus Disease 2019 (COVID-19) in 850 Patients
- PMID: 32773328
- PMCID: PMC7392075
- DOI: 10.1016/j.acra.2020.07.031
Imaging Findings of SARS-CoV-2 Infection in Pediatrics: A Systematic Review of Coronavirus Disease 2019 (COVID-19) in 850 Patients
Abstract
Rationale and objectives: Children with COVID-19 seem to have a relatively milder disease and better prognosis; however, severe disease or death could still occur in this age group. Although the knowledge on the clinical and epidemiology of COVID-19 in pediatric patients is being accumulated rapidly, relevant comprehensive review on its radiological manifestations is still lacking. The present article reviews the radiological characteristics of COVID-19 in pediatrics, based on the previous studies.
Materials and methods: We conducted a systematic literature search for published articles by using Medline, Scopus, Google Scholar and Embase online databases. All studies describing CT findings of COVID-19 in pediatrics (<18years) were included.
Results: A total of 39 studies with 850 pediatric patients were reviewed. 225 (26.5%) of patients had normal CT findings. Ground-glass opacities and consolidations were the most common CT abnormalities (384/625, 61.5%). Other findings were halo sign, interstitial opacities, bronchial wall thickening, and crazy-paving sign. Approximately 55% of patients had unilateral pulmonary findings. Most studies found peripheral and lower-lobe distribution to be a prominent imaging finding.
Conclusion: Our study showed that imaging findings in children were often milder and more focal than adults, typically as ground-glass opacities and consolidations with unilateral lower-lobe predominance, which have been regressed during the recovery time. A balance must be struck between the risk of radiation and the need for chest CT. If still necessary, low-dose CT is more appropriate in this age group. Albeit, due to the limited number of reported pediatrics with COVID-19, and the lack of consistency in CT descriptors, further work is still needed in this regard.
Keywords: COVID-19; CT-scan; Chest imaging; Children; Lung; Pediatrics; Pneumonia; Radiation; SARS-CoV-2.
Copyright © 2020 The Association of University Radiologists. Published by Elsevier Inc. All rights reserved.
Figures

Comment in
-
Comment on "Imaging Findings of SARS-CoV-2 Infection in Pediatrics: A Systematic Review of Coronavirus Disease 2019 (COVID-19) in 850 Patients".Acad Radiol. 2021 Oct;28(10):1480. doi: 10.1016/j.acra.2021.07.021. Epub 2021 Aug 9. Acad Radiol. 2021. PMID: 34412943 Free PMC article. No abstract available.
References
Publication types
MeSH terms
LinkOut - more resources
Full Text Sources
Medical
Miscellaneous